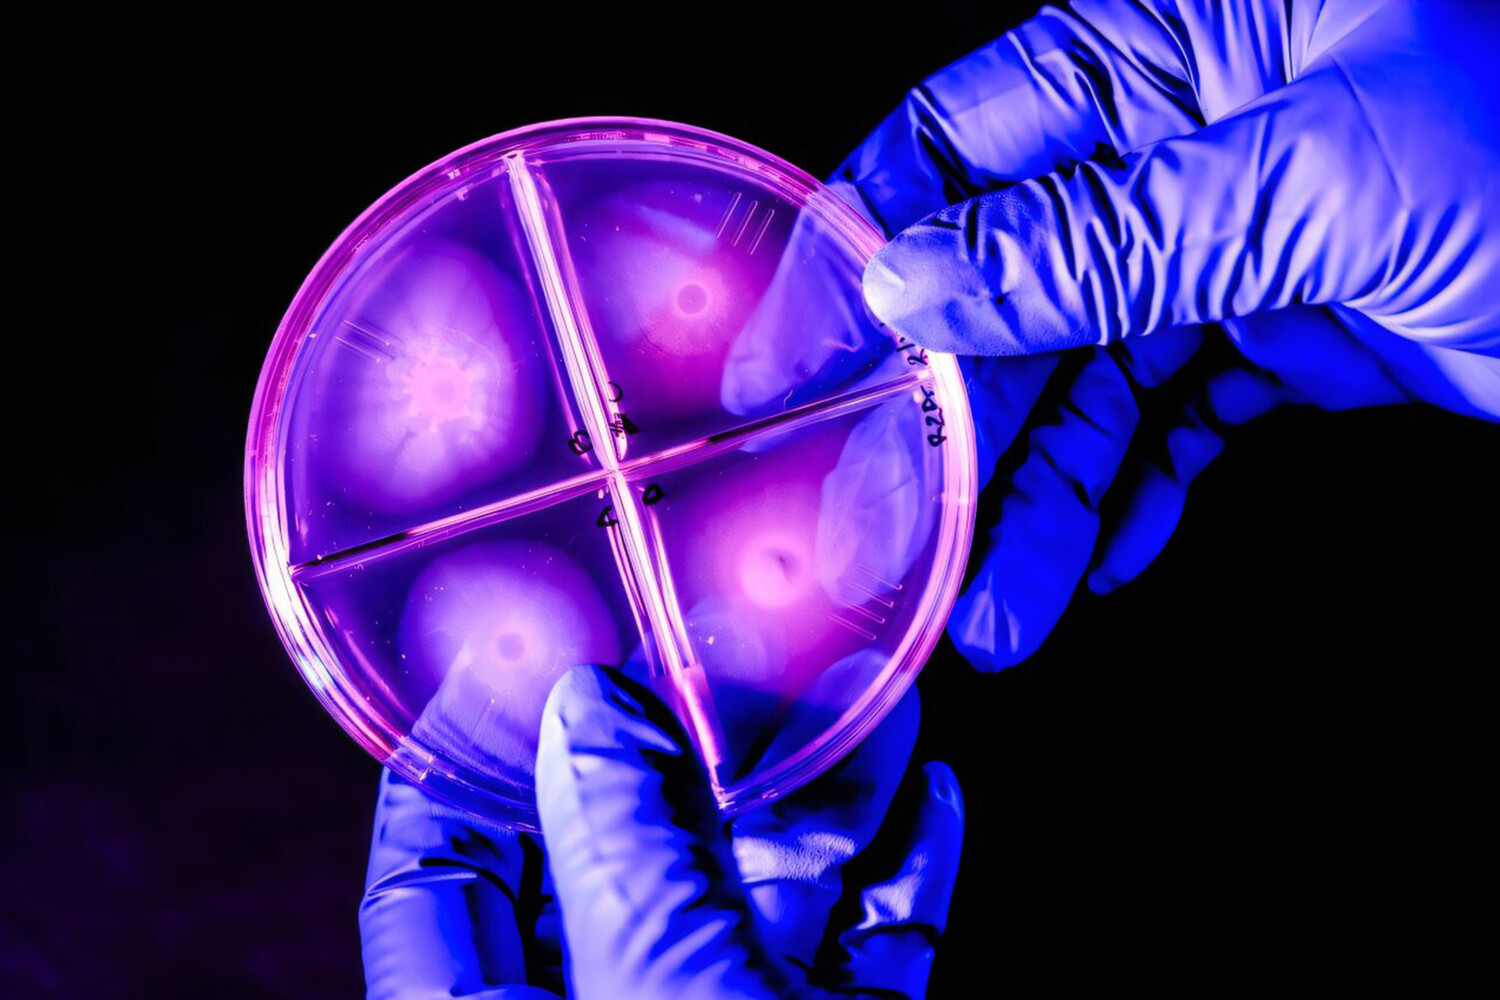

В южной части Чили, в Патагонии ученые обнаружили загадочные «живые камни». Оказалось, это гигантские бактериальные биопленки, возраст которых составляет миллиарды лет. Работа опубликована в журнале Microbiology Resource Announcements (MRA).
Эти древние образования, называемые строматолитами, представляют собой кальцифицированные слои бактерий, накапливавшиеся на протяжении эпох. Они появились на Земле задолго до людей, наших предков-приматов и, возможно, даже до появления многоклеточных организмов.
Во время экспедиции группа профессора биологии и биохимии Северо-Восточного университета Вероники Годой-Картер обнаружила необычную бактерию из рода Janthinobacterium, обладающую ярко-фиолетовым цветом. Эта бактерия формирует прочные биопленки, настолько крепкие, что они могут удерживать жидкость в пробирке, словно крышка.
Кроме того, Janthinobacterium — экстремофил, способный выживать при отрицательных температурах, что делает его потенциально ценным объектом для исследований.
«Такие многоклеточные сообщества бактерий считаются первыми организованными живыми клетками на Земле», — отметила Годой-Картер.
Исследователи уже расшифровали геном Janthinobacterium, что позволит выделить наиболее интересные гены и внедрить их в более «сговорчивые» лабораторные бактерии.
«Эта бактерия не хочет сотрудничать», — пошутила ученая, — «Поэтому нам нужно переместить ее гены в более подходящий организм».
Ученые надеются, что их открытия помогут в создании новых биоразлагаемых пластиков, текстиля, а также материалов с защитой от ультрафиолетового излучения благодаря уникальному фиолетовому пигменту.
«Бактерии — это самые удивительные организмы на Земле. Они могут жить без нас, а мы без них — нет», — подытожила Годой-Картер.
Ранее культовая австралийская птица раскрыла свой скрытый талант.